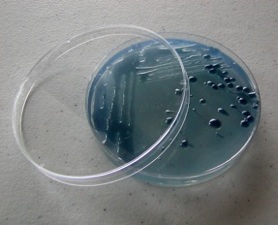

The Latest from Boing Boing |  |
- New fiction: "The Jammie Dodgers and the Adventure of the Leicester Square Screening"
- Why the absence of copyright is good for fashion
- Pro-masturbation article from 1959
- Mad World + Death Metal Scream = Eleanor Rigby
- Keyboard shortcuts
- Ploom review
- Joule iPad stand review
- Aluratek Libre review
- Image: Derek Yu does Mario
- BP: "The solution will not be televised" / UPDATED
- Hurricane Katrina reduced levels of lead in New Orleans soil/children
- Handfish: Pretty much exactly what they sound like
- Iraq: CIA's aborted psyops stunt to discredit Saddam? "Pedo-Hussein" sex tapes
- Valve parody Apple's 1984 ad for Half-Life 2 Mac teaser
- Mark on Twit.tv at 2pm Pacific time 5/25/2010
- David Byrne sues FL gov over unauthorized use of "Road to Nowhere" in senate campaign ad
- 7 Copyright Questions for Canada's DMCA Minister
- Artificial butterfly for studying insect flight
- Kid-made science kits
- North Korea severs all ties with South Korea, both sides amp up propaganda
- Petri Dish Soap in the Boing Boing Bazaar
- Report: Obama to send 1,200 troops to Mexico border for "intelligence, surveillance, reconnaissance"
- Big Picture: Saturn and vicinity
- Amityville Horror home for sale
- Libraries of Flesh: The sorry state of human tissue storage
- Beware the hybrid bear
- The Wild and Wonderful Whites of West Virginia
| New fiction: "The Jammie Dodgers and the Adventure of the Leicester Square Screening" Posted: 26 May 2010 02:56 AM PDT Shareable.net has just kicked off a new fiction series, "Visions of a Shareable Future," with stories about a future in which sharing is part of the norm. I have the inaugural story, "The Jammie Dodgers and the Adventure of the Leicester Square Screening," which I wrote as a kind of run-up to getting to work on my next YA novel, Pirate Cinema, which will likely be a 2011 Tor Teens title. Both "Jammie Dodgers" and Pirate Cinema are the story of streetkids in London who remix movies and screen them in impromptu theaters -- the sides of derelict pubs, ancient graveyards, vaulted Victorian sewers -- and establish an alternative to the mainstream Hollywood industry. Shareable: The Jammie Dodgers and the Adventure of the Leicester Square Screening (Image: Tilt and shift - Leicester Square at night, a Creative Commons Attribution Non-Commercial No-Derivative-Works (2.0) image from rthakrar's photostream) |
| Why the absence of copyright is good for fashion Posted: 26 May 2010 02:35 AM PDT Here's Johanna Blakley from USC's Ready to Share project describing how the lack of copyright restrictions on fashion has improved the field -- everybody has to constantly invent, everybody can use anything from the fashion world as the basis for invention, and the result is a never-ending (and highly profitable) cycle of innovation. Johanna Blakely: Lessons from fashion's free culture (via /.) |
| Pro-masturbation article from 1959 Posted: 26 May 2010 02:30 AM PDT  Here's a surprisingly progressive pro-masturbation article written by a minister for Sexology magazine in 1959: Still another kind of experience is illustrated in the case of Harley Smith. Harley was initiated into the practice at an early age among a gang of boys. Curiosity then led him to experiment himself.A Minister Discusses SELF-GRATIFICATION (Jan, 1959) |
| Mad World + Death Metal Scream = Eleanor Rigby Posted: 26 May 2010 02:24 AM PDT PeaceLove sez, "My friend Sean travels from a Gary Julesesque "Mad World" to a death metal roar "Imagine" to "Eleanor Rigby." I had always known he was talented but this one blew me away; his control throughout is astonishing and he's a pretty damn strong keyboardist as well." Mad World Imagine Eleanor Rigby Numb (Thanks, PeaceLove!)
|
| Posted: 26 May 2010 12:10 AM PDT |
| Posted: 25 May 2010 09:23 PM PDT  Ploom is a wee butane-powered vaporizer that has a cigarette-esque form factor and produces enough smoke to make it feel like a smoke. So far, so good. Unfortunately, it requires proprietary pods, none of which contain weed, and parts of it get hot on the outside. It's an amazing little sci-fi gadget -- a bit like a fancy mechanical pencil -- though not really something I want inside of me. The smoke I found curiously unsatisfying, too, but I smoke cigars. So your mileage may vary. And it's just $30. Product Page Ploom is a wee butane-powered vaporizer that has a cigarette-esque form factor and produces enough smoke to make it feel like a smoke. So far, so good. Unfortunately, it requires proprietary pods, none of which contain weed, and parts of it get hot on the outside. It's an amazing little sci-fi gadget -- a bit like a fancy mechanical pencil -- though not really something I want inside of me. The smoke I found curiously unsatisfying, too, but I smoke cigars. So your mileage may vary. And it's just $30. Product Page |
| Posted: 25 May 2010 09:09 PM PDT  Element Case's Joule is a premium iPad stand. A heavy, polished block of metal that looks like a work of art — or perhaps a discarded industrial component — it comes with a detachable metal bar that can be adjusted three ways for different viewing angles. As far as designer iPad stands go, it's hard to imagine something fancier that is not completely absurd. As it is, this one is expensive enough: $130 solves your exceedingly first-world problem. It's gorgeous, but there's a flaw! There's no way to snake the charging cord into it, so it can't do charging duty. P.S. It strikes me is how this and, say, a $1 business card holder, each exemplify the two poles of 'minimalism.' Joule is the end that costs a lot, is beautiful, lasts forever, simplifies decisively, but carries a vague whiff of ubiquitous consumption in unnecessary places. The $1 business card holder seems more truthful in that it offers the bare minimum required to fulfill its function, but is actually a bit crap. All in all, it's easy to see why one would pay $30 for the one from Apple that actually charges the damned iPad. Element Case Joule Element Case's Joule is a premium iPad stand. A heavy, polished block of metal that looks like a work of art — or perhaps a discarded industrial component — it comes with a detachable metal bar that can be adjusted three ways for different viewing angles. As far as designer iPad stands go, it's hard to imagine something fancier that is not completely absurd. As it is, this one is expensive enough: $130 solves your exceedingly first-world problem. It's gorgeous, but there's a flaw! There's no way to snake the charging cord into it, so it can't do charging duty. P.S. It strikes me is how this and, say, a $1 business card holder, each exemplify the two poles of 'minimalism.' Joule is the end that costs a lot, is beautiful, lasts forever, simplifies decisively, but carries a vague whiff of ubiquitous consumption in unnecessary places. The $1 business card holder seems more truthful in that it offers the bare minimum required to fulfill its function, but is actually a bit crap. All in all, it's easy to see why one would pay $30 for the one from Apple that actually charges the damned iPad. Element Case Joule |
| Posted: 25 May 2010 10:11 PM PDT  Aluratek's Libre reader gets it: it's cheap — $150 list, $100 at Sears — and fills the long-form reading niche that brightly-screened tablets like the iPad can't serve, but which no-one is going to spend a lot of money on anymore. There are compromises: it's slow to flip pages and is not a pretty thing at all. Furthermore, the display doesn't seem as nice as other readers, either. Sony's superior Pocket Reader is also only a little more expensive. But it is more expensive, so if you're just looking for something quasi-disposable to replace airport paperbacks, here you go. It even comes with a free SD card, loaded with out-of-copyright classics. Amazon Link Aluratek's Libre reader gets it: it's cheap — $150 list, $100 at Sears — and fills the long-form reading niche that brightly-screened tablets like the iPad can't serve, but which no-one is going to spend a lot of money on anymore. There are compromises: it's slow to flip pages and is not a pretty thing at all. Furthermore, the display doesn't seem as nice as other readers, either. Sony's superior Pocket Reader is also only a little more expensive. But it is more expensive, so if you're just looking for something quasi-disposable to replace airport paperbacks, here you go. It even comes with a free SD card, loaded with out-of-copyright classics. Amazon Link |
| Posted: 25 May 2010 02:30 PM PDT  Spelunky and Aquaria creator Derek Yu does big tribute to little Mario in this image for Giant Robot's 2008 Game Over show that's somehow slipped under my radar until now. Yu's also responsible for this wicked Doom tribute in this year's show, and more than a few other fantastic illustrations (including... Lady Gaga?). [via BigTig] Spelunky and Aquaria creator Derek Yu does big tribute to little Mario in this image for Giant Robot's 2008 Game Over show that's somehow slipped under my radar until now. Yu's also responsible for this wicked Doom tribute in this year's show, and more than a few other fantastic illustrations (including... Lady Gaga?). [via BigTig] Previously: |
| BP: "The solution will not be televised" / UPDATED Posted: 25 May 2010 05:01 PM PDT Update: BP's official Twitter account just posted word that yes, the spew-surveillance internet video feed will continue during Wednesday's attempt to stop the flow. Not this account, maintained by pranksters, but the legit one. Though it's not like the presence of a live video feed in and of itself will make things any better, stop the destruction, or clean up what's already devastated. And for the record, I don't agree with Markey's outrage over a web video "blackout." After all, if the attempted fix doesn't work, I wish these bastards all the luck in the world trying to hide that...
(YouTube link). BP today announced that it plans to disable the happy-fun live internet video feed of oil spewing at the bottom of the Gulf of Mexico while BP engineers try to stop up the well using a procedure they call "top kill." Rep. Edward Markey, chairman of the House subcommittee on energy and the environment, was not amused: "It is outrageous that BP would kill the video feed for the top kill. This BP blackout will obscure a vital moment in this disaster," Markey said in a statement. "After more than a month of spewing oil into the Gulf of Mexico, BP is essentially saying to the American people the solution will not be televised."And in related news, Federal government inspectors overseeing oil drilling in the Gulf "accepted meals and tickets to sporting events from companies they monitored," reported the Interior Department's inspector general. |
| Hurricane Katrina reduced levels of lead in New Orleans soil/children Posted: 25 May 2010 02:59 PM PDT When the flood waters of Hurricane Katrina receded from New Orleans, some of the city's dangerously high lead levels washed away, too. Prior to the Hurricane, 15 neighborhoods had soil lead levels higher than the federal standard. Tests done in the same places post-Katrina found only 6 neighborhoods exceeding the limit. Across 29 neighborhoods, lead levels dropped an average of 45% between 2000 and 2006—a change attributed to Katrina as the levels had sat, basically unchanged, between 1990 and 2000. The effect shows up in kids, as well as the yards they play in. On average, New Orleans' children under the age of six experienced a 30% drop in blood lead levels. |
| Handfish: Pretty much exactly what they sound like Posted: 25 May 2010 02:44 PM PDT  Handfish are fish. They have fins that look an awful lot like hands. Instead of swimming, they walk on these fins. If you ever suspected that anything remotely approaching the status of "missing link" would end up looking patently ridiculous—congratulations, you're right. At that handfish's expense. Above is a pink handfish, one of nine newly identified species of the handfish family. Only four specimens of pink handfish have ever been found. And nobody has spotted a living one since 1999. (The inevitable crushing self-esteem issues must be keeping them out of public view.) The line between different species, in this case, seems to be mostly drawn along physical differences, according to National Geographic, which has organized the wide array of handfish diversity into a fascinating slideshow. |
| Iraq: CIA's aborted psyops stunt to discredit Saddam? "Pedo-Hussein" sex tapes Posted: 25 May 2010 03:09 PM PDT  In the run-up to America's 2003 invasion of Iraq, a CIA team brainstormed ways to attack public perception of Saddam Hussein among Iraqis. One of the psyops plans was to "flood Iraq with videos" that depicted the dictator having sex with a teenage boy. The CIA hoax "hidden camera" videos were to be shot "very grainy, like it was a secret videotaping of a sex session," according to a former official familiar with the plan. In the run-up to America's 2003 invasion of Iraq, a CIA team brainstormed ways to attack public perception of Saddam Hussein among Iraqis. One of the psyops plans was to "flood Iraq with videos" that depicted the dictator having sex with a teenage boy. The CIA hoax "hidden camera" videos were to be shot "very grainy, like it was a secret videotaping of a sex session," according to a former official familiar with the plan. The agency actually did make a video purporting to show Osama bin Laden and his cronies sitting around a campfire swigging bottles of liquor and savoring their conquests with boys, one of the former CIA officers recalled, chuckling at the memory. The actors were drawn from "some of us darker-skinned employees," he said.Man oh man, my kingdom for a torrent. Anyway, just one problem with the CIA's man-boy-love-tape plans:
"Saddam playing with boys would have no resonance in the Middle East -- nobody cares," [said a] former CIA official with extensive experience in the region. "Trying to mount such a campaign would show a total misunderstanding of the target. We always mistake our own taboos as universal when, in fact, they are just our taboos."CIA unit's wacky idea: Depict Saddam as gay (Washington Post) |
| Valve parody Apple's 1984 ad for Half-Life 2 Mac teaser Posted: 25 May 2010 02:17 PM PDT Taking their original Apple print ad parodies to the next logical level, Half Life and Portal creators Valve have just released (as in, minutes ago -- hold steady if the YouTube upload quality's still not the greatest) this teaser trailer for Half Life 2's release by giving Apple's classic 1984 ad the full City 17 treatment. The OSX version of the game will be coming tomorrow to their new Mac version of Steam. Previously: |
| Mark on Twit.tv at 2pm Pacific time 5/25/2010 Posted: 25 May 2010 01:50 PM PDT I'll be on Net@Night on Twit.tv with Leo Laporte and Amber Mac in a few minutes. I'll talk about Boing Boing, Make, and my new book, Made by Hand. |
| David Byrne sues FL gov over unauthorized use of "Road to Nowhere" in senate campaign ad Posted: 25 May 2010 01:52 PM PDT David Byrne is suing the Republican governor of Florida, Charlie Crist, because Crist used the great Byrne/Talking Heads track "Road to Nowhere" in a campaign ad (Crist is now running for senate). Byrne writes: Well, using a recording of a song, or even just using that song and not the original recording, in an advertisement without permission is illegal, unless the composition has gone into the public domain. It's not just illegal because one is supposed to pay for such use and not paying is, well, theft -- it's also illegal because one has to ask permission, and that permission can be turned down. 05.25.10: Yours Truly vs. the Governor of Florida (David Byrne's journal) More about the lawsuit on Billboard.com. Talking Heads: Little Creatures (album link @ Amazon)
|
| 7 Copyright Questions for Canada's DMCA Minister Posted: 25 May 2010 12:51 PM PDT Michael Geist sez, With reports that a Canadian DMCA could be introduced this week, thousands of Canadians have been expressing concern with the government's plans, as there are mounting fears that the results from last summer's copyright consultation may be shelved in favour of a repeat of the much-criticized Bill C-61.Seven Copyright Questions for Canadian Heritage Minister James Moore |
| Artificial butterfly for studying insect flight Posted: 25 May 2010 12:57 PM PDT The beautiful rubber band-powered artificial butterfly is helping researchers understand the flight of swallowtails. Hiroto Tanaka of Harvard University and Isao Shimoyama of the University of Tokyo built the balsa-wood machine, which boasts thin polymer film wings with "veins" made with a silicon-etching technique. The artificial butterfly enables them to control the flight mechanisms in ways they couldn't do with live butterflies. From Science News: "Artificial butterfly mixes high, low tech" |
| Posted: 25 May 2010 12:50 PM PDT I met 15-year-old Connor at a signing in Raleigh-Durham. He asked great questions and was a fun audience member, but even so, he blew me away when he revealed after the talk that he's been making and selling science kits for kids since he was nine, and has built a modest and successful business out of this, and uses his proceeds and his profile to give talks about entrepreneurship at struggling schools without much science curriculum. They're cool kits, and Connor's a fantastic kid. Kits for Kids (Thanks, Connor!) |
| North Korea severs all ties with South Korea, both sides amp up propaganda Posted: 25 May 2010 01:00 PM PDT  The government of North Korea today announced it would sever all ties with South Korea, further exacerbating conflict over accusations that the North sank a warship belonging to the South. North Korea's state news agency said all communications between the countries would be cut, including a Red Cross border contact, and that various transportation links would also be blocked. The government of North Korea today announced it would sever all ties with South Korea, further exacerbating conflict over accusations that the North sank a warship belonging to the South. North Korea's state news agency said all communications between the countries would be cut, including a Red Cross border contact, and that various transportation links would also be blocked. US Secretary of State Hilary Clinton is in the region, and said yesterday that the March 26th naval attack by Pyongyang, in which 46 sailors died, would not go "unanswered." The US and South Korea plan joint military exercises. Snip from Guardian UK: The South's military resumed propaganda radio broadcasts across the border this morning after a six-year hiatus, with programmes airing news, western music and comparisons of the political and economic situations on the two parts of the peninsula. The psychological warfare will enrage the North, which has warned it will fire at any propaganda facilities in the demilitarised zone.(Image from the Official Website of the Democratic People's Republic of Korea)
|
| Petri Dish Soap in the Boing Boing Bazaar Posted: 25 May 2010 12:43 PM PDT Cleaner Science handcrafts soap inside petri dishes! My favorite is the E. Coli Transformation (pearberry) that glows in the dark! They're $9.50 each in the Boing Boing Bazaar! Petri Dish Soaps |
| Report: Obama to send 1,200 troops to Mexico border for "intelligence, surveillance, reconnaissance" Posted: 25 May 2010 01:04 PM PDT Reports are circulating that US president Barack Obama will deploy 1,200 National Guard troops to the Mexican border. AP: Obama will also request $500 million for border protection and law enforcement activities, they said. The National Guard troops will work on intelligence, surveillance, reconnaissance and blocking drug trafficking. |
| Big Picture: Saturn and vicinity Posted: 25 May 2010 12:08 PM PDT  The Big Picture lovingly curated a magnificent selection of Saturn images snapped by the Cassini probe. Above, Saturn's moon Enceladus "continues to spew ice into space, seen by Cassini on October 14, 2009." For even more dazzling images and the backstory of Cassini's extended mission, check out Maggie Koerth-Baker's Boing Boing megafeature from March, "Cassini: Trip Reset." |
| Amityville Horror home for sale Posted: 25 May 2010 12:11 PM PDT   This lovely five-bedroom home at 108 Ocean Avenue in Amityville, New York is now for sale for $1.15 million. Who cares? Well, 108 Ocean Avenue used to be 112 Ocean Avenue, where Ronald DeFeo Jr. killed his family in 1974 and, several years later, the Lutz family were traumatized by things that go bump in the night. The original Amityville Horror address, and spooky windows, were changed by previous owners to keep away creep-seekers. The real estate listing refers to it as a "legendary home" but does not mention flies, blood streaming from the walls, or a demon pig named Jodie. From Newsday: James Cromarty, 77, bought the house in 1977. By that point, a bank had foreclosed on the house from the Lutzes, who have since died. DeFeo is at the upstate Green Haven Correctional Facility, serving 25 years to life for the murders.'Amityville Horror' house back on market, for $1.15M (Newsday) The Amityville Files |
| Libraries of Flesh: The sorry state of human tissue storage Posted: 25 May 2010 11:33 AM PDT  A must-read feature from Steve Silberman in this month's Wired: State-of-the-art medical care and research are increasingly dependent on the storage of human cells and tissue in cryogenic facilities called biobanks. Located in universities, hospitals, and private institutions all over the world, these archives of the human organism are the biological back end of data-driven medicine.Libraries of Flesh: video, images, and text. (Photo: Andrew Tingle) |
| Posted: 25 May 2010 11:11 AM PDT  Boing Boing reader Inuvik Phil says, "This soundslide from the Canadian Broadcasting Corporation shows a hunter from Ulukhaktok, NWT (Population ~400) telling the story of killing a strange bear. Many hybrid bears have been found recently, with traits of both polar and grizzly bears." Boing Boing reader Inuvik Phil says, "This soundslide from the Canadian Broadcasting Corporation shows a hunter from Ulukhaktok, NWT (Population ~400) telling the story of killing a strange bear. Many hybrid bears have been found recently, with traits of both polar and grizzly bears." |
| The Wild and Wonderful Whites of West Virginia Posted: 25 May 2010 10:14 AM PDT  ☠ All cameras aimed at a grinning Johnny Knoxville—flanked by a bluegrass band—outside the theater where "The Wild and Wonderful Whites of West Virginia" made its Los Angeles debut. The "Jackass" star served as the film's executive producer, which might lead one to assume it's the same sort of death-cheating, stunt comedy stuff for which Knoxville is known. There is plenty of death-cheating in "Whites," but it's no comedy. The documentary, directed by Julien Nitzberg, follows the legacy of the White family of Boone County, West Virginia. Their most famous living member is Jesco White, star of the 1991 cult documentary hit "Dancing Outlaw" (on which Nitzberg was associate producer).
The Appalachian clan is notorious for criminal activity and reckless, larger-than-life characters. They tap-dance, shoot and stab people (including each other), and sell (and do) a lot of drugs. Think "Sopranos" meets "Coal Miner's Daughter."
A personal detour here: I was conceived in West Virginia, not far from the Whites' stomping grounds. To their credit, my parents got out as fast as possible. I thank them for it. Most of the people I know from West Virginia talk about the state the way soldiers talk about Iraq: it's a place to get out of. The only people born there who stay there, the saying goes, are the ones too poor to escape. There are two archetypal forms of livelihood: coal miner, and an approximation of what the Whites are. Scary hillbillies.
Probably, the Whites.
THE WILD AND WONDERFUL WHITES OF WEST VIRGINIA A film by Julien Nitzberg shot in Boone County, West Virginia
|
| You are subscribed to email updates from Boing Boing To stop receiving these emails, you may unsubscribe now. | Email delivery powered by Google |
| Google Inc., 20 West Kinzie, Chicago IL USA 60610 | |

 You can fit eight Jammie Dodgers into a single-occupancy Leicester Square hotel room. Provided that they don't all try to breathe in at once. We breathe in shifts.
You can fit eight Jammie Dodgers into a single-occupancy Leicester Square hotel room. Provided that they don't all try to breathe in at once. We breathe in shifts.  "We can't ask insects, like 'Hey, please just flap your wings at 10 hertz,'" Tanaka says... To mimic the way the butterflies might use their front and rear wings together, the researchers created one big wing for each side of the body...
"We can't ask insects, like 'Hey, please just flap your wings at 10 hertz,'" Tanaka says... To mimic the way the butterflies might use their front and rear wings together, the researchers created one big wing for each side of the body...
















No comments:
Post a Comment